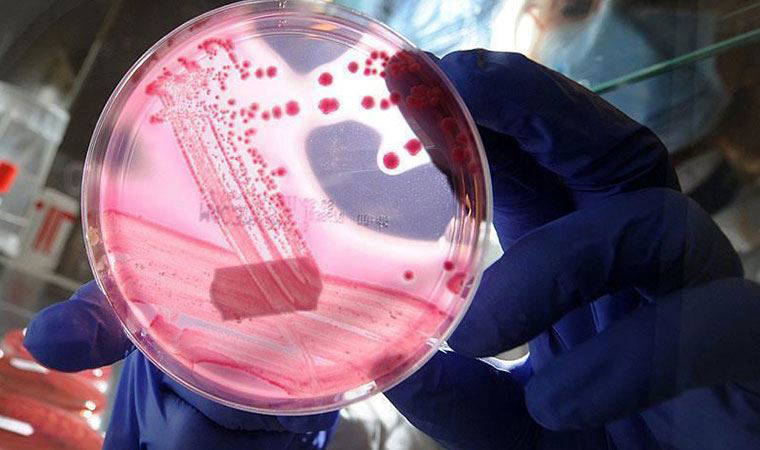
Meme kanserinde tümörün daha hızlı büyümesine yol açan protein bulundu

Dr. Özsan, kadınların meme çevresindeki kırmızı döküntüler, memedeki çukurlaşmalar ve meme başının içeri çekilmesi gibi belirtilere karşı uyanık olmalarını önerdi.
GÖĞÜSTE ÇUKUR ÖNEMLİ BİR BELİRTİ
Meme kanseri farkındalık ayında hastalığın belirtileri ile ilgili bilgi veren Op.Dr. İsmail Özsan, her 5 kadından 1'ine yaygın belirtiler dışında şikayetlerle kanser teşhisi konulduğuna dikkat çekti. Kadınlar arasında en yaygın görülen kanser çeşidi olan meme kanserinde erken tanının önemine değinen Op.Dr. Özsan, "Göğüste çukurlaşma meme kanseri açısından önemli bir belirtidir. Çukurlar, genellikle tümörün deriyi çekmesinden kaynaklanır ve önemli bir habercidir. Meme kanseri hastalarında zaman zaman meme ucunda içeri doğru çekilmeler gözlemlenmektedir. Bu konuda önemli olan şudur. Eğer meme başı çökük iken meme uyarıldığında çıkmıyorsa, kanserden şüphelenilmesi gerekir. Meme derisinin portakal kabuğu görüntüsünde olması da önemli bir belirtidir. Bu durumda meme kanserinin ilerlediğini söylemek mümkündür” dedi.
MEME ÇEVRESİNDE KIRMIZI DÖKÜNTÜLER
Göğüste, meme ucunda ve çevresinde görülen kırmızı pul pul döküntülerin de ciddiye alınması gereken bir belirti olduğunu ifade eden Op.Dr. Özsan, "Bu kızarıklıkların elbette başka bir sebebi de olabilir ancak kızarıklık bir kaç hafta geçmiyorsa bir uzmana gösterilmesi gerekmektedir. Kırmızı, şişmiş ve hassas göğüsler iltihaplı meme kanseri belirtileri arasında sayılmaktadır. Bir başka belirti olan meme başı akıntıları da açık renk ya da kırmızımsı kan renginde ise hemen bir uzmana başvurulmalıdır" diye konuştu.
RAKAMLARLA MEME KANSERİ
Genetik geçişli ya da ailevi meme kanserleri, tüm meme kanserlerinin yüzde 15’ini oluşturur.
Türkiye’de hayat boyu her 22 kadından birinde meme kanseri görülmektedir. Meme kanseri tanısı konan 6 kadından biri 40 yaşın altındadır.